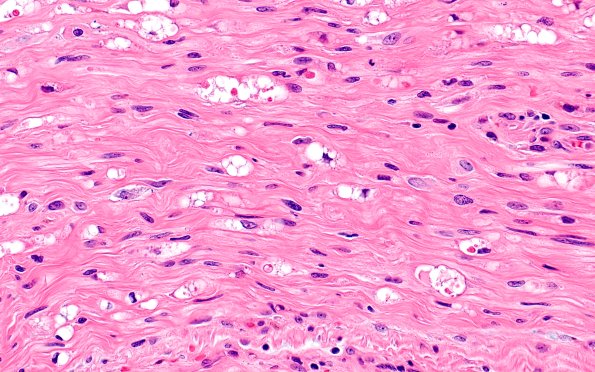
3A3 Axonal Degeneration (Case 3) H&E 40X

Table of Contents
Washington University Experience | PERIPHERAL NEUROPATHY | 4 AXONAL DEGENERATION | 1 H&E & IHC | 3A3 Axonal Degeneration (Case 3) H&E 40X
This is a longitudinal section of one nerve fascicle showing degenerating globular debris consistent with surgical trauma from the original tumor resection. Some fascicles (not shown) show nearly normal axonal preservation (H&E)